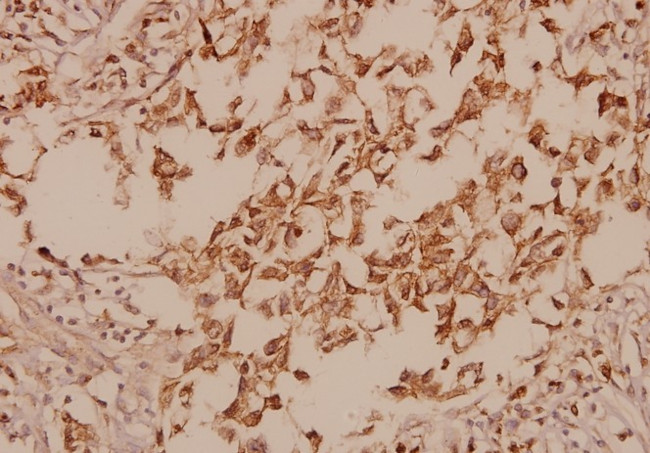
GAD67 Antibody in Immunohistochemistry (Paraffin) (IHC (P))

Search
Invitrogen
GAD67 Polyclonal Antibody
{{$productOrderCtrl.translations['antibody.pdp.commerceCard.promotion.promotions']}}
{{$productOrderCtrl.translations['antibody.pdp.commerceCard.promotion.viewpromo']}}
{{$productOrderCtrl.translations['antibody.pdp.commerceCard.promotion.promocode']}}: {{promo.promoCode}} {{promo.promoTitle}} {{promo.promoDescription}}. {{$productOrderCtrl.translations['antibody.pdp.commerceCard.promotion.learnmore']}}

Please note: We are reviewing Western blot images included in the antibody testing data in our catalog, including those provided by third parties. Unless expressly labeled or annotated as “raw-unedited”, Western blot images included in the antibody testing data in our catalog may have been edited, optimized or otherwise adjusted for presentation.
产品信息
PA5-36054
种属反应
已发表种属
宿主/亚型
分类
类型
抗原
偶联物
形式
浓度
规格
纯化类型
保存液
内含物
保存条件
运输条件
RRID
产品详细信息
This antibody detects endogenous protein at a molecular weight of 67 kDa.
Purity is >95% by SDS-PAGE.
靶标信息
GAD-65 and GAD-67 are members of the group II decarboxylase family of proteins and are responsible for catalyzing the rate limiting step in the production of GABA (gamma-aminobutyric acid) from L-glutamic acid. Although both GADs are found in the brain, GAD-65 localizes to synaptic vesicle membranes in nerve terminals, while GAD-67 is distributed throughout the cell. GAD-67 is responsible for the basal levels of GABA synthesis. In the case of a heightened demand for GABA in neurotransmission, GAD-65 will transiently activate to assist in GABA production. The loss of GAD-65 is detrimental and can impair GABA neurotransmission, however the loss of GAD-67 is lethal. Due to alternative splicing, two isoforms exist for GAD-67: the predominant GAD-67 form and the minor GAD-25 form.
仅用于科研。不用于诊断过程。未经明确授权不得转售。
生物信息学
蛋白别名: 67 kDa glutamic acid decarboxylase; FLJ45882; GAD; GAD 1; GAD 67; GAD-67; GAD67 short splice variant; Glutamate decarboxylase 1; glutamate decarboxylase 1 (brain 67kDa) isoform GAD1_1; glutamate decarboxylase 1 (brain 67kDa) isoform GAD1_2; glutamate decarboxylase 1 (brain 67kDa) isoform GAD1_3; Glutamate decarboxylase 1 (brain); glutamate decarboxylase 1 (brain, 67kDa); glutamate decarboxylase 1 variant GAD67NT; Glutamate decarboxylase 67 kDa isoform; GLUTAMATE DECARBOXYLASE, 67 KD ISOFORM (GAD-67) (67 KD GLUTAMIC ACID DECARBOXYLASE); glutamic acid decarboxylase 1; OTTHUMP00000041055; unnamed protein product
基因别名: CPSQ1; DEE89; EP10; GAD; Gad-1; GAD-67; GAD1; GAD25; GAD44; GAD67; SCP
UniProt ID: (Mouse) P48318, (Rat) P18088
Entrez Gene ID: (Human) 2571, (Mouse) 14415, (Rat) 24379